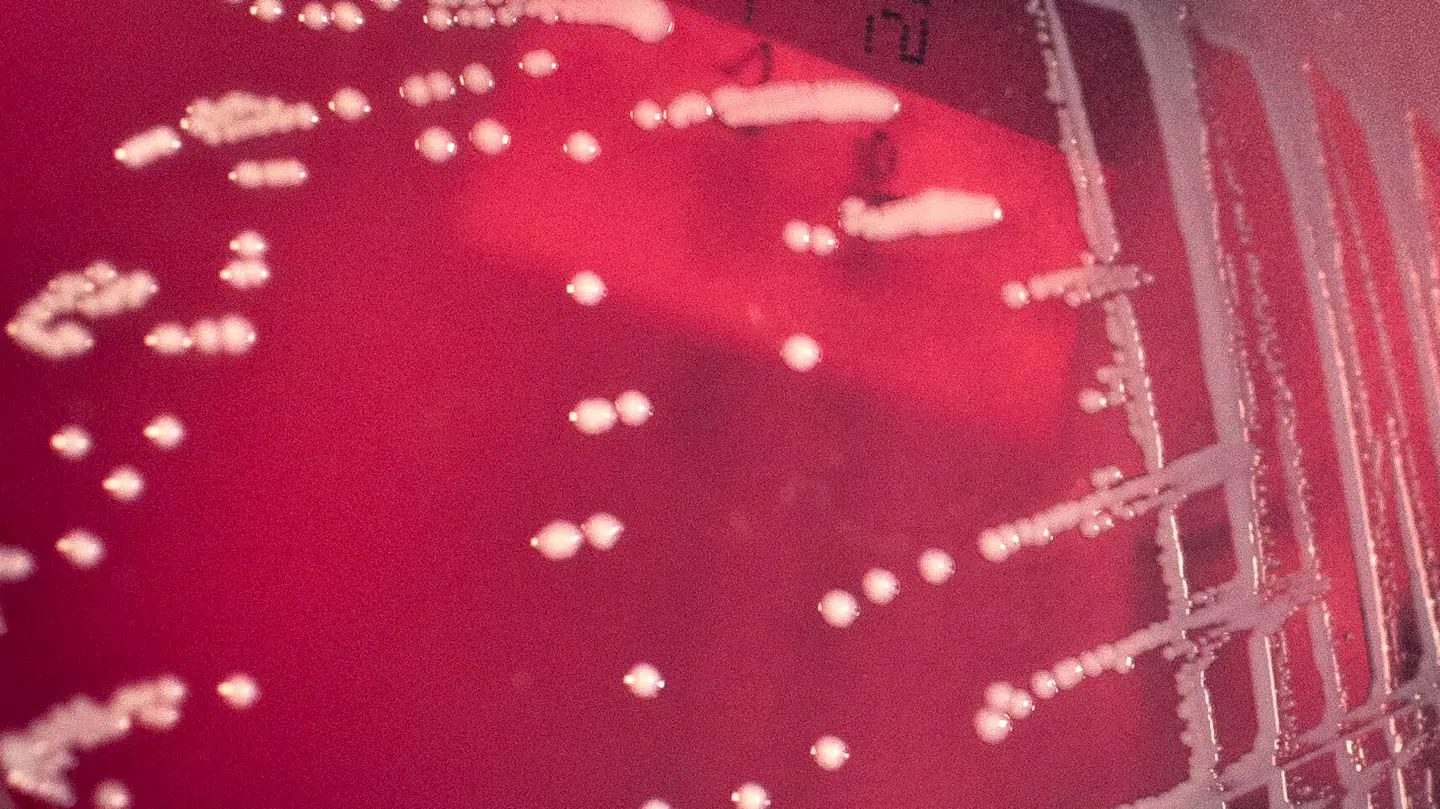
Billede af gruppe A streptokokker-bakterier, der blandt andet kan føre til nekrotiserende fasciitis.

Tre britiske kvinder ramt af livsfarlig infektion: Nu advarer ekspert

På kort tid har tre britiske kvinder fået en sjælden og farlig infektion, og nu advarer eksperter imod sygdommen.
Kvinderne blev ramt af en kødædende infektion forskellige steder i Storbritannien kaldet nekrotiserende fasciitis, som kan blive livstruende inden for 24 til 48 timer.
I en rapport i tidsskriftet BMJ Case Reports, fortæller lægerne ifølge Dagbladet, at de tre kvinder pådrog sig infektionen i deres ydre kønsorganer, herunder skamlæberne og det omkringliggende område.
»Nekrotiserende fasciitis opstår, når bakterier trænger ind i huden. Det kan ske via små sår, forbrændinger, operationer eller endda insektbid,« siger professor Bill Sullivan ved Indiana University.
Han fortæller, at infektionen kan opstå overalt på kroppen – også i den nederste del af maven.
Den ene af kvinderne fik antibiotika efter at have opdaget en lille plet på sine kønsorganer. Fem dage senere havde infektionen spredt sig til maven og hoften.
Hun døde af blodforgiftning 28 timer efter, at hun fik diagnosen.
Selvom den sjældne infektionen er svær at undgå, når den først rammer, er der alligevel én ting, man selv kan gøre.
»Hurtig operation er ofte nødvendig for at redde liv og forhindre spredning,« siger Bill Sullivan i rapporten.